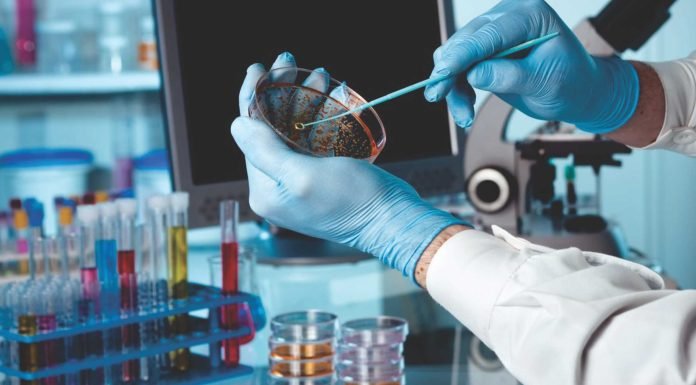
FEED FOR THOUGHT – Safety Based & Future Focused

” Sometimes the simplest things are the most profound. My job is to bring out in people & what they wouldn’t dare do themselves “
NUQO Animal Nutrition India Announces Two Key Appointments in North India...
NUQO Animal Nutrition India Pvt. Ltd. has announced the appointment of two experienced professionals, Yogesh Srivastav and Prashant Kurele as Regional Sales Managers in...
Pan India Broiler Coordination Committee – Nationwide Promotional Activities Report
The Pan India Broiler Coordination Committee (PIBCC) has been consistently working for the past 8–10 years to promote chicken consumption and educate consumers across...
One Week to Go — Don’t Miss VICTAM Asia & Health...
With just two weeks to go before opening the doors, VICTAM Asia 2026 and Health & Nutrition Asia 2026 are preparing to welcome industry...
Trouw Nutrition Global Mycotoxin Review Delivers Insights to Support Feed...
Trouw Nutrition 2025 Global Mycotoxin Review deploys robust model to identify threats to manage in 2026 feed formulation and livestock production
(AMERSFOORT, THE NETHERLANDS...
De Heus successfully completes acquisition of CJ Feed & Care, marking...
Ede, the Netherlands, March 3 - De Heus Animal Nutrition is pleased to announce the successful completion of the acquisition of CJ Feed &...
Cargill opens INR 300 crore dairy feed plant in Punjab, strengthens...
Cargill Animal Nutrition & Health has inaugurated a state-of-the-art dairy feed plant at Wazirabad, Punjab, with an investment of INR 300 crore, reaffirming its...
Bhuvana NBS & Andres Pintaluba S.A. (APSA) Spain Strengthen Poultry Health...
Bhuvana Nutribio Sciences India, in collaboration with Andres Pintaluba S.A. (APSA), Spain, successfully conducted the 4th Technical Seminar under the Bhuvana–Pintaluba Tech Series on...
Trouw Nutrition 2025 Global Mycotoxin Review deploys robust model to identify...
Trouw Nutrition, Nutreco’s livestock feed business, is sharing findings on the levels of mycotoxin contamination in 2025 feed ingredients, silage, and complete feeds. As...
De Heus successfully completes acquisition of CJ Feed & Care, marking...
De Heus Animal Nutrition is pleased to announce the successful completion of the acquisition of CJ Feed & Care from CJ Cheil Jedang
This strategic...
IPEMA–Poultry India Showcases Strong Global Presence at 2026 International Production &...
IPEMA–Poultry India marked its significant presence at the 2026 International Production & Processing Expo (IPPE), Atlanta — one of the world’s leading annual events...
Indian Firm Secures USD 4.5 Million for Mega BSF Facility
Elmentoz Research Pvt. Ltd. has raised USD 4.5 million in its first seed funding round to expand insect-based protein production and promote antibiotic-free animal...
U.S. Farmers to Plant More Soybeans, Less Corn in 2026 Amid...
U.S. farmers are set to increase soybean plantings and scale back corn acreage in 2026, according to the U.S. Department of Agriculture (USDA), even...
Kerala to Launch High-Tech Centre for Indigenous Cattle Breeding and Milk...
The Kerala Livestock Development Board (KLDB) is establishing a Centre of Excellence for Advanced Technologies in Bovine Production and Research (ATBPRC) at its Kulathupuzha...
EW Group to Invest INR 200 Crore to Expand Layer Chick...
Germany-based agribusiness EW Group plans to invest INR 200 crore in India's poultry sector over the next three years through its newly formed subsidiary,...
SOPA Opposes GM Soybean Meal Imports, Cites Strong Domestic Supply
The Soybean Processors Association of India (SOPA) has urged Commerce Minister Piyush Goyal to reject the poultry industry's request to import genetically modified (GM)...
India’s Oilmeal Exports Drop 42% in January on Weak Soybean and...
India's oilmeal exports fell sharply in January 2026, declining 42% year-on-year to 2,60,123 tonnes, driven by weaker shipments of soybean and rapeseed meals, according...
Long-Standing Feed and Fodder Issues Continue to Hinder Livestock and Fisheries...
Feed and fodder shortages, infrastructure gaps, and dependence on a narrow export basket remain major hurdles for India's livestock and fisheries sectors, according to...
India’s Maize Paradox: Rising Policy Support but Farmers Struggle with Prices
India's maize sector is at a crossroads, reflecting a stark contrast between government support and ground-level farmer distress. With over 1.69 crore operational holdings...
Summer Management Strategies for Commercial Layers
With the India Meteorological Department (IMD) forecasting another exceptionally hot year in 2026, effective heat-stress management in commercial layers has become essential for sustaining...
Subclinical Mastitis: A Hidden Challenge Affecting the Feed Mill
In India's competitive dairy feed industry, feed mills invest heavily in formulating high-performance products to improve productivity. However, a largely unseen challenge—subclinical mastitis—can significantly...